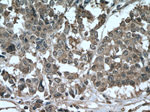
AKAP13 Antibody in Immunohistochemistry (Paraffin) (IHC (P))

Search
Proteintech
AKAP13 Polyclonal Antibody
{{$productOrderCtrl.translations['antibody.pdp.commerceCard.promotion.promotions']}}
{{$productOrderCtrl.translations['antibody.pdp.commerceCard.promotion.viewpromo']}}
{{$productOrderCtrl.translations['antibody.pdp.commerceCard.promotion.promocode']}}: {{promo.promoCode}} {{promo.promoTitle}} {{promo.promoDescription}}. {{$productOrderCtrl.translations['antibody.pdp.commerceCard.promotion.learnmore']}}
产品信息
27947-1-AP
种属反应
宿主/亚型
分类
类型
抗原
偶联物
形式
浓度
规格
纯化类型
保存液
内含物
保存条件
运输条件
产品详细信息
Immunogen sequence: MIVEEENTD RSCRKKNKGV ERKGEEVEPA PIVDSGTVSD QDSCLQSLPD CGVKGTEGLS SCGNRNEETG TKSSGMPTDQ ESLSSGDAVL QRDLVMEPGT AQYSSGGELG GISTTNVSTP DTAGEMEHGL MNPDATVWKN VLQGGESTKE RFENSNIGTA GASDVHVTSK PVDKISVPNC APAASSLDGN KPAESSLAFS NEETSTEKTA ETETSRSREE SADAPVDQNS V (359-587 aa encoded by NM_001270546)
靶标信息
The A-kinase anchor proteins (AKAPs) are a group of structurally diverse proteins which have the common function of binding to the regulatory subunit of protein kinase A (PKA) and confining the holoenzyme to discrete locations within the cell. This gene encodes a member of the AKAP family. Alternative splicing of this gene results in multiple transcript variants encoding different isoforms containing c-terminal dbl oncogene homology (DH) and pleckstrin homology (PH) domains. The DH domain is associated with guanine nucleotide exchange activation for the Rho/Rac family of small GTP binding proteins, resulting in the conversion of the inactive GTPase to the active form capable of transducing signals. The PH domain has multiple functions. Therefore, these isoforms function as scaffolding proteins to coordinate a Rho signaling pathway, function as protein kinase A-anchoring proteins and, in addition, enhance ligand-dependent activity of estrogen receptors alpha and beta.
仅用于科研。不用于诊断过程。未经明确授权不得转售。
篇参考文献 (0)
生物信息学
蛋白别名: A kinase (PRKA) anchor protein 13; A-kinase anchor protein 13; AKAP-13; AKAP-Lbc; AKAP-Lbc; guanine nucleotide exchange factor; Breast cancer nuclear receptor-binding auxiliary protein; Brx/Proto-Lbc; Guanine nucleotide exchange factor Lbc; Human thyroid-anchoring protein 31; LBC oncogene; Lymphoid blast crisis oncogene; Non-oncogenic Rho GTPase-specific GTP exchange factor; p47; PRKA13; Protein kinase A-anchoring protein 13; unnamed protein product
基因别名: AKAP-13; AKAP-Lbc; AKAP13; ARHGEF13; BRX; c-lbc; HA-3; HT31; LBC; p47; PRKA13; PROTO-LB; PROTO-LBC
UniProt ID: (Human) Q12802
Entrez Gene ID: (Human) 11214